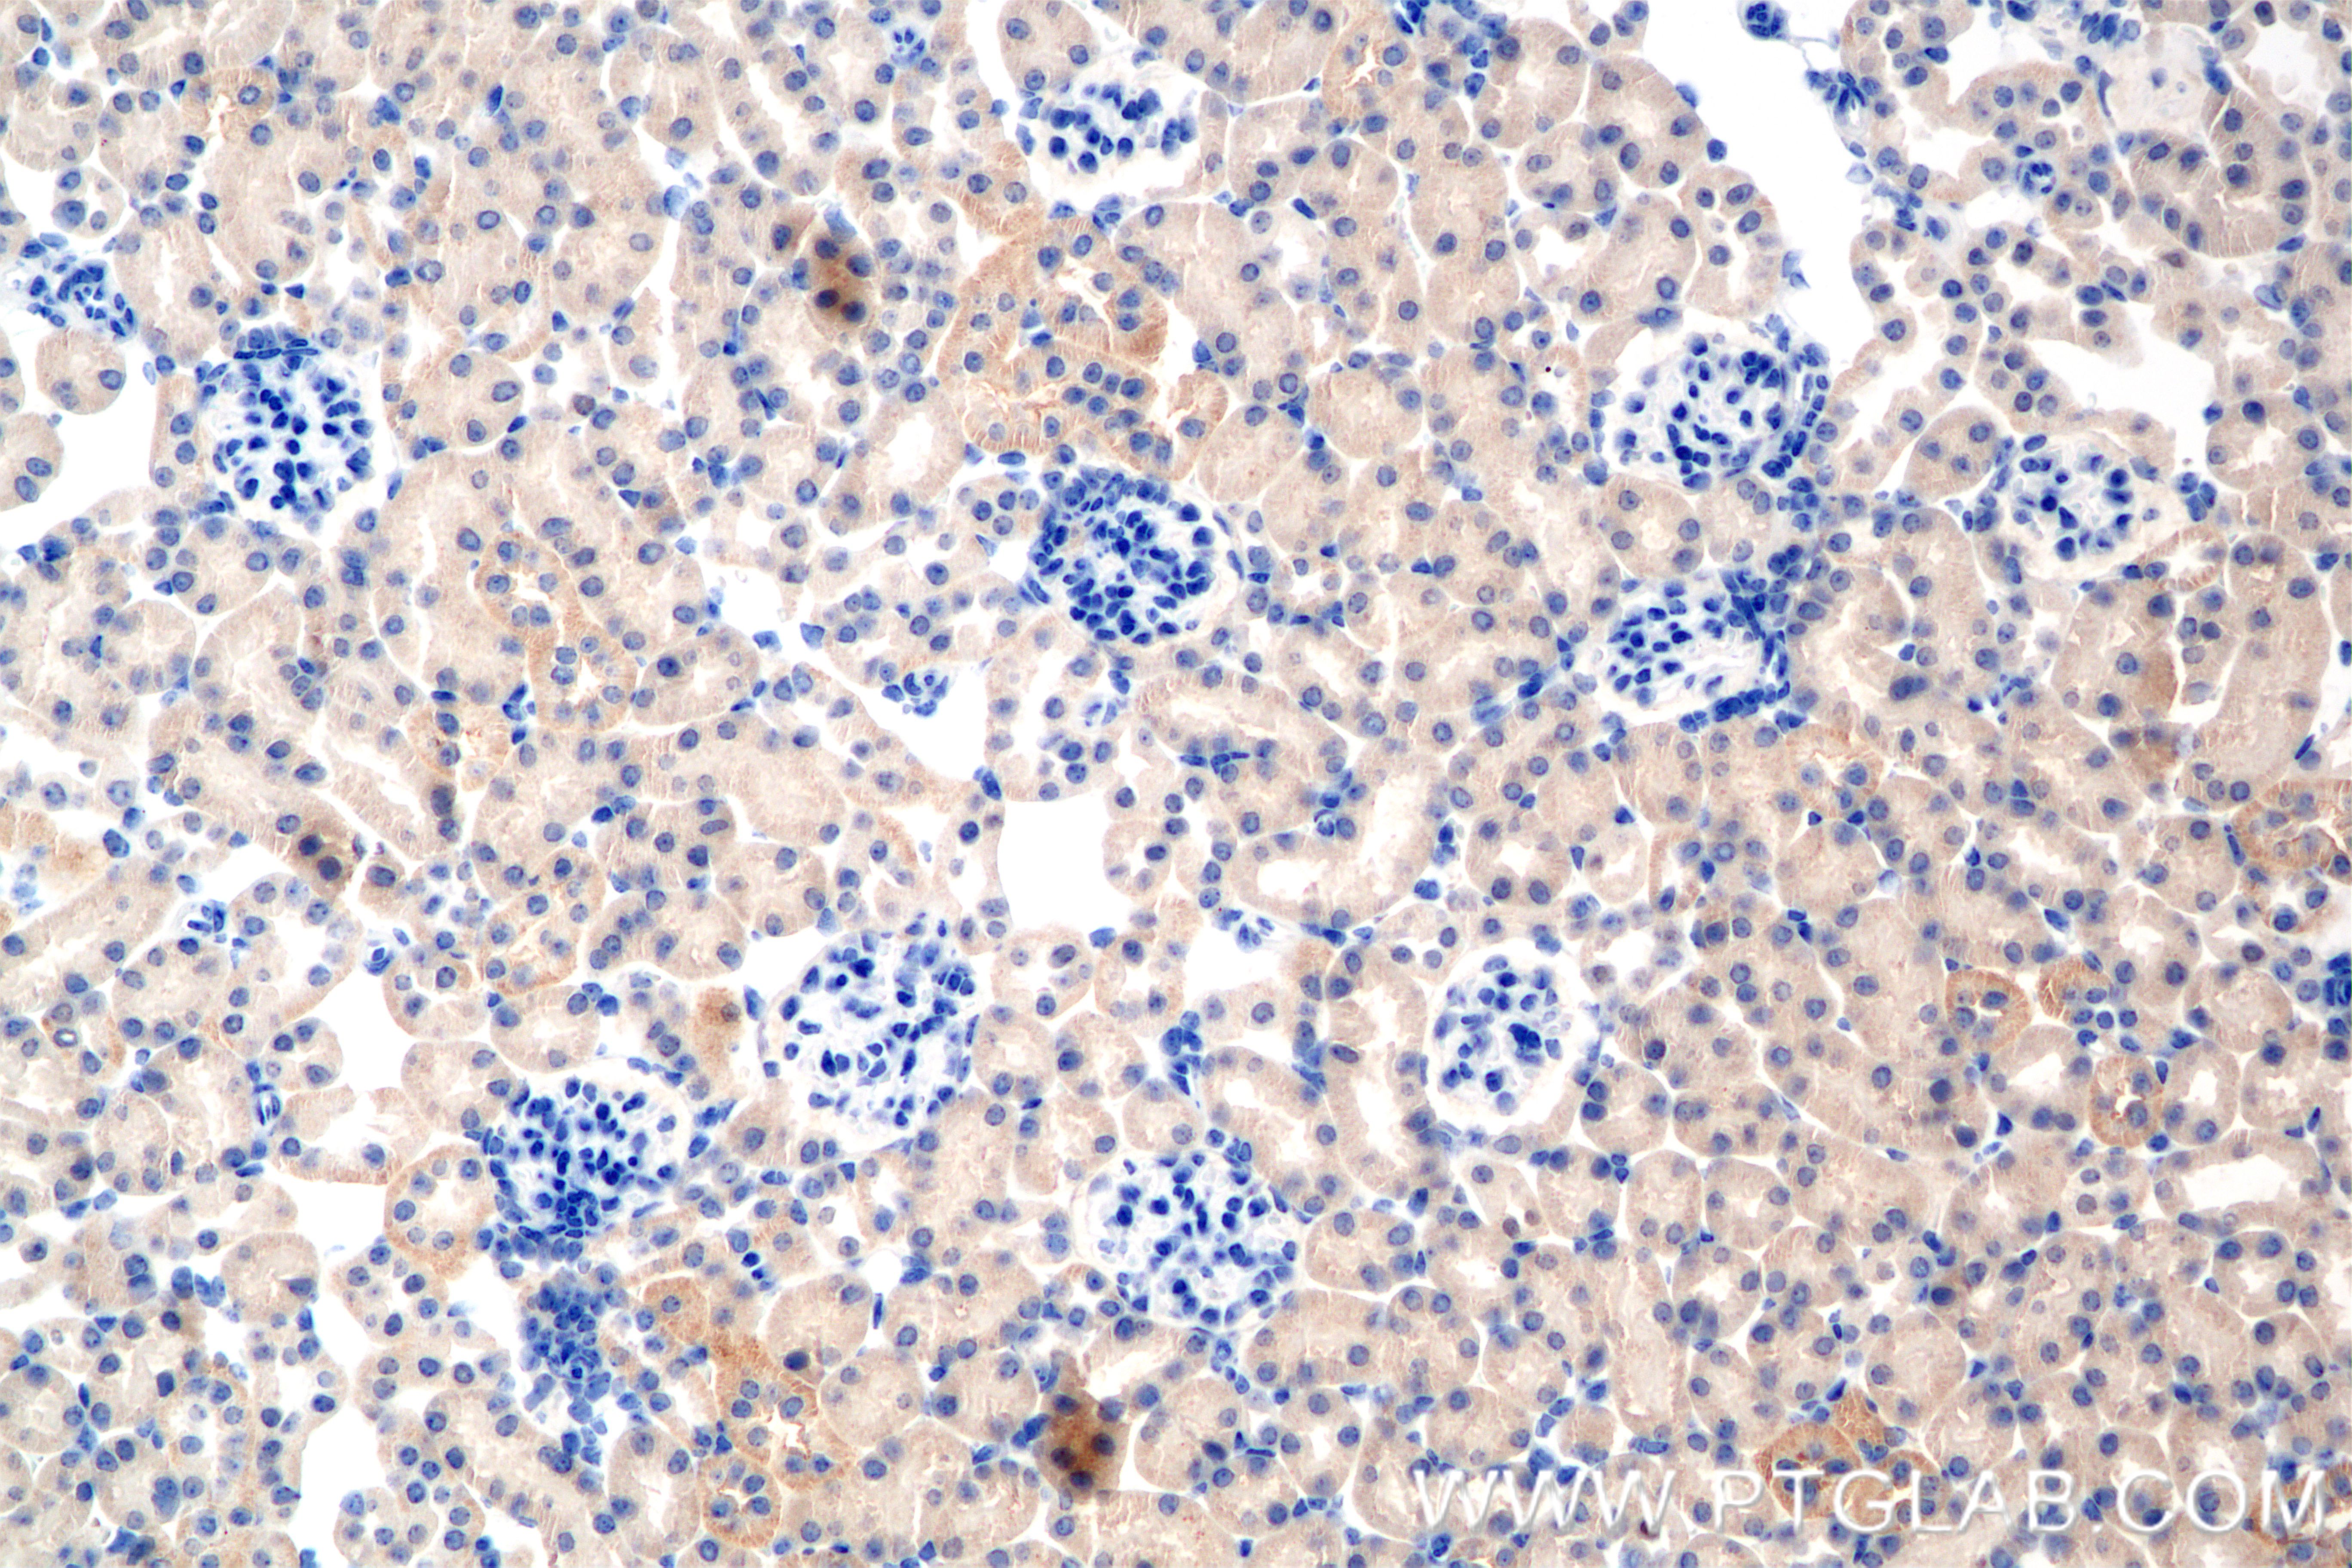
IHC staining of mouse kidney using 82989-4-RR

验证数据展示
经过测试的应用
| Positive WB detected in | Cobalt Chloride treated NIH/3T3 cells |
| Positive IHC detected in | mouse kidney tissue Note: suggested antigen retrieval with TE buffer pH 9.0; (*) Alternatively, antigen retrieval may be performed with citrate buffer pH 6.0 |
推荐稀释比
| 应用 | 推荐稀释比 |
|---|---|
| Western Blot (WB) | WB : 1:5000-1:50000 |
| Immunohistochemistry (IHC) | IHC : 1:200-1:800 |
| It is recommended that this reagent should be titrated in each testing system to obtain optimal results. | |
| Sample-dependent, Check data in validation data gallery. | |
发表文章中的应用
| KD/KO | See 1 publications below |
| WB | See 6 publications below |
| IHC | See 1 publications below |
产品信息
82989-4-RR targets Hif-1 alpha in WB, IHC, ELISA applications and shows reactivity with mouse samples.
| 经测试应用 | WB, IHC, ELISA Application Description |
| 文献引用应用 | WB, IHC |
| 经测试反应性 | mouse |
| 文献引用反应性 | mouse |
| 免疫原 |
CatNo: Ag33620 Product name: Recombinant mouse Hif1a protein Source: e coli.-derived, PGEX-4T Tag: GST Domain: 530-825 aa of NM_001313919 Sequence: SEYCFDVDSDMVNVFKLELVEKLFAEDTEAKNPFSTQDTDLDLEMLAPYIPMDDDFQLRSFDQLSPLESNSPSPPSMSTVTGFQQTQLQKPTITATATTTATTDESKTETKDNKEDIKILIASPSSTQVPQETTTAKASAYSGTHSRTASPDRAGKRVIEQTDKAHPRSLNLSATLNQRNTVPEEELNPKTIASQNAQRKRKMEHDGSLFQAAGIGTLLQQPGDCAPTMSLSWKRVKGFISSEQNGTEQKTIILIPSDLACRLLGQSMDESGLPQLTSYDCEVNAPIQGSRNLLQG* 种属同源性预测 |
| 宿主/亚型 | Rabbit / IgG |
| 抗体类别 | Recombinant |
| 产品类型 | Antibody |
| 全称 | hypoxia inducible factor 1, alpha subunit |
| 别名 | Hif1a, 230101E8, ARNT-interacting protein, Hif-1a, HIF1alpha |
| 计算分子量 | 93 kDa |
| 观测分子量 | 120 kDa |
| GenBank蛋白编号 | NM_001313919 |
| 基因名称 | Hif1a |
| Gene ID (NCBI) | 15251 |
| RRID | AB_3670737 |
| 偶联类型 | Unconjugated |
| 形式 | Liquid |
| 纯化方式 | Protein A purfication |
| UNIPROT ID | Q61221 |
| 储存缓冲液 | PBS with 0.02% sodium azide and 50% glycerol, pH 7.3. |
| 储存条件 | Store at -20°C. Stable for one year after shipment. Aliquoting is unnecessary for -20oC storage. |
实验方案
| Product Specific Protocols | |
|---|---|
| IHC protocol for Hif-1 alpha antibody 82989-4-RR | Download protocol |
| WB protocol for Hif-1 alpha antibody 82989-4-RR | Download protocol |
| Standard Protocols | |
|---|---|
| Click here to view our Standard Protocols |
发表文章
| Species | Application | Title |
|---|---|---|
Carbohydr Polym Carboxymethyl chitosan and sodium alginate oxide pH-sensitive dual-release hydrogel for diabetes wound healing: The combination of astilbin liposomes and diclofenac sodium | ||
ACS Appl Mater Interfaces Photothermally Activated Multifunctional Hydrogel with Bioactive Carbon Nanomaterials for Accelerated Diabetic Wound Healing. | ||
PLoS One Integrated RNA-seq and scRNA-seq to explore the biological mechanisms of mitophagy-related genes in ulcerative colitis. | ||
Acta Biomater Adhesive polyethylene glycol hydrogels with metformin enabling in-situ drug delivery reprogramming immuno-metabolism for tissue repair in diabetic foot ulcers. | ||
Eur J Histochem miR-199a-5p inhibited HIF-1α to suppress the proliferation, migration, and differentiation of cardiac stem cells.
| ||
Mater Today Bio Immediate tumor killing and long-term anti-tumor immunoreaction induced by Bufalin-loaded phototherapeutic Janus membrane in CRC postoperative therapy. |